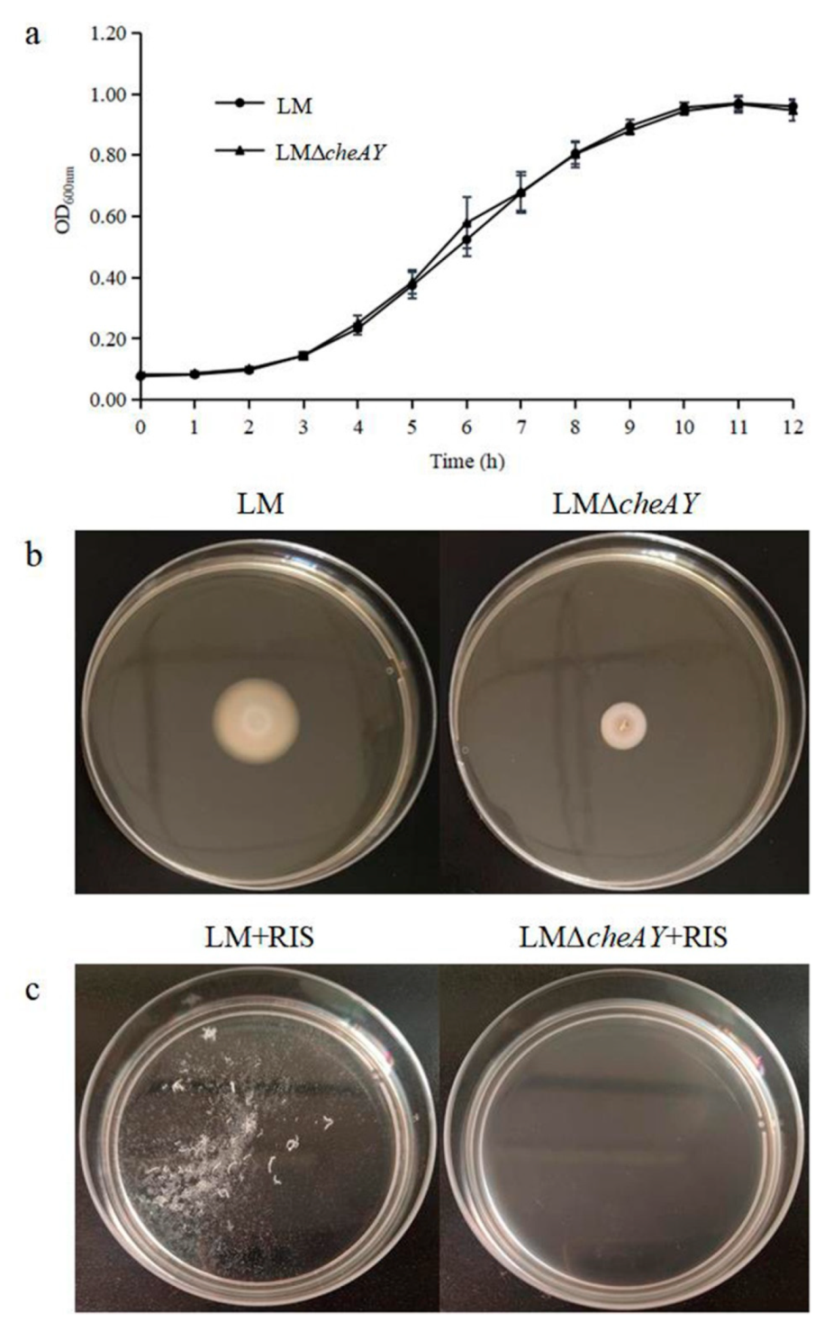

Gene Analysis of Listeria monocytogenes Suspended Aggregates Induced by Ralstonia insidiosa Cell-Free Supernatants under Nutrient-Poor Environments
Abstract
:1. Introduction
2. Materials and Methods
2.1. Bacterial Strains and Growth Media
2.2. Preparation of Suspended Aggregates
2.2.1. Suspended Aggregate Formation of L. Monocytogenes
2.2.2. Suspended Aggregate Formation of L. Monocytogenes Induced by 10% RIS
2.3. Scanning Electron Microscopic Observation of Suspended Aggregates
2.4. Preparation of Sequencing Samples
2.4.1. L. Monocytogenes Sample
2.4.2. Suspended Aggregate Sample
2.5. Extraction and Purification of RNA from Suspended Aggregates or L. monocytogenes
2.6. Library Construction and Sequencing
2.7. Differentially Expressed Genes Analysis
2.8. GO and KEGG Pathway Enrichment Analyses
2.9. Construction of Deletion Strains
2.10. The Strain Growth and Motility Assay
2.11. Determination of the Ability to Form Suspended Aggregates
2.12. Statistical Analysis
3. Results
3.1. Preparation and Scanning Electron Microscopic Observation of Suspended Aggregates
3.2. Quality Control of Sequencing Data
3.3. Analysis of DEGs
3.4. GO Enrichment Analysis of DEGs
3.5. KEGG Enrichment Analysis of DEGs
3.6. Analysis of Essential DEGs
3.7. The Role of cheA and cheY in Strain Growth and Motility of L. monocytogenes
3.8. cheA and cheY are Involved in Suspended Aggregate Formation in L. monocytogenes
4. Discussion
5. Conclusions
Supplementary Materials
Author Contributions
Funding
Institutional Review Board Statement
Informed Consent Statement
Data Availability Statement
Conflicts of Interest
References
- Dortet, L.; Radoshevich, L.; Veiga, E.; Cossart, P. Listeria monocytogenes☆. In Encyclopedia of Microbiology, 4th ed.; Schmidt, T.M., Ed.; Academic Press: Oxford, UK, 2019; pp. 803–818. [Google Scholar]
- Welshimer, H.J.; Donkervo, J. Listeria monocytogenes in nature. Appl. Microbiol. 1971, 21, 516–519. [Google Scholar] [CrossRef]
- Lassen, S.G.; Ethelberg, S.; Bjorkman, J.T.; Jensen, T.; Sorensen, G.; Jensen, A.K.; Muller, L.; Nielsen, E.M.; Molbak, K. Two listeria outbreaks caused by smoked fish consumption-using whole-genome sequencing for outbreak investigations. Clin. Microbiol. Infect. 2016, 22, 620–624. [Google Scholar] [CrossRef] [Green Version]
- Boatemaa, S.; Barney, M.; Drimie, S.; Harper, J.; Korsten, L.; Pereira, L. Awakening from the listeriosis crisis: Food safety challenges, practices and governance in the food retail sector in South Africa. Food Control 2019, 104, 333–342. [Google Scholar] [CrossRef]
- Soon, J.M.; Brazier, A.K.M.; Wallace, C.A. Determining common contributory factors in food safety incidents—A review of global outbreaks and recalls 2008–2018. Trends Food Sci. Technol. 2020, 97, 76–87. [Google Scholar] [CrossRef]
- Coenye, T.; Goris, J.; De Vos, P.; Vandamme, P.; LiPuma, J.J. Classification of Ralstonia pickettii-like isolates from the environment and clinical samples as Ralstonia insidiosa sp nov. Int. J. Syst. Evol. Microbiol. 2003, 53, 1075–1080. [Google Scholar] [CrossRef]
- Ryan, M.P.; Pembroke, J.T.; Boatemaa, C.C. Genotypic and phenotypic diversity of Ralstonia pickettii and Ralstonia insidiosa isolates from clinical and environmental sources including High-purity Water. Diversity in Ralstonia pickettii. BMC Microbiol. 2011, 11, 194. [Google Scholar] [CrossRef] [Green Version]
- Liu, N.T.; Bauchan, G.R.; Francoeur, C.B.; Shelton, D.R.; Lo, Y.M.; Nou, X. Ralstonia insidiosa serves as bridges in biofilm formation by foodborne pathogens Listeria monocytogenes, Salmonella enterica, and Enterohemorrhagic Escherichia coli. Food Control 2016, 65, 14–20. [Google Scholar] [CrossRef] [Green Version]
- Stoodley, P.; Sauer, K.; Davies, D.G.; Costerton, J.W. Biofilms as complex differentiated communities. Annu. Rev. Microbiol. 2002, 56, 187–209. [Google Scholar] [CrossRef] [Green Version]
- Ramalingam, B.; Sekar, R.; Boxall, J.B.; Biggs, C.A. Aggregation and biofilm formation of bacteria isolated from domestic drinking water. Water Sci. Technol. Water Supply 2013, 13, 1016–1023. [Google Scholar] [CrossRef]
- Leff, L.; Van Gray, J.B.; Marti, E.; Merbt, S.N.; Romani, A.M. Aquatic Biofilms: Ecology, Water Quality and Wastewater Treatment; Caister Academic Press: Wymondham, UK, 2016; Volume 36. [Google Scholar]
- Grantcharova, N.; Peters, V.; Monteiro, C.; Zakikhany, K.; Romling, U. Bistable expression of CsgD in biofilm development of Salmonella enterica Serovar Typhimurium. J. Bacteriol. 2010, 192, 456–466. [Google Scholar] [CrossRef] [Green Version]
- White, A.P.; Gibson, D.L.; Grassl, G.A.; Kay, W.W.; Finlay, B.B.; Vallance, B.A.; Surette, M.G. Aggregation via the red, dry, and rough morphotype is not a virulence adaptation in Salmonella enterica serovar typhimurium. Infect. Immun. 2008, 76, 1048–1058. [Google Scholar] [CrossRef] [Green Version]
- Simoes, L.C.; Simoes, M.; Vieira, M.J. Biofilm interactions between distinct bacterial genera isolated from drinking water. Appl. Environ. Microbiol. 2007, 73, 6192–6200. [Google Scholar] [CrossRef] [Green Version]
- Trunk, T.; Khalil, H.S.; Leo, J.C. Bacterial autoaggregation. AIMS microbiology 2018, 4, 140–164. [Google Scholar] [CrossRef]
- Guo, A.; Xu, Y.; Mowery, J.; Nagy, A.; Bauchan, G.; Nou, X. Ralstonia insidiosa induces cell aggregation of Listeria monocytogenes. Food Control 2016, 67, 303–309. [Google Scholar] [CrossRef] [Green Version]
- Rao, D.; Webb, J.S.; Kjelleberg, S. Competitive interactions in mixed-species biofilms containing the marine bacterium Pseudoalteromonas tunicata. Appl. Environ. Microbiol. 2005, 71, 1729–1736. [Google Scholar] [CrossRef] [Green Version]
- Nielsen, S.M.; Norskoy-Lauritsen, N.; Bjarnsholt, T.; Meyer, R.L. Achromobacter Species Isolated from Cystic Fibrosis Patients Reveal Distinctly Different Biofilm Morphotypes. Microorganisms 2016, 4, 33. [Google Scholar] [CrossRef] [Green Version]
- Toh, Y.S.; Yeoh, S.L.; Yap, I.K.S.; Teh, C.S.J.; Win, T.T.; Thong, K.L.; Chong, C.W. Role of coaggregation in the pathogenicity and prolonged colonisation of Vibrio cholerae. Med. Microbiol. Immunol. 2019, 208, 793–809. [Google Scholar] [CrossRef]
- Wimpenny, J.; Colasanti, R. A simple cellular automaton model for coaggregation. Biofilms 2005, 1, 369–375. [Google Scholar] [CrossRef]
- Zhong, J.; Zhao, X. Transcriptomic Analysis of Viable but Non-Culturable Escherichia coli O157:H7 Formation Induced by Low Temperature. Microorganisms 2019, 7, 634. [Google Scholar] [CrossRef] [PubMed] [Green Version]
- Zhang, X.; Ruan, Y.; Liu, W.; Chen, Q.; Gu, L.; Guo, A. Transcriptome Analysis of Gene Expression in Dermacoccus abyssi HZAU 226 under Lysozyme Stress. Microorganisms 2020, 8, 707. [Google Scholar] [CrossRef] [PubMed]
- Chen, Q.; Li, Q.; Guo, A.; Liu, L.; Gu, L.; Liu, W.; Zhang, X.; Ruan, Y. Transcriptome analysis of suspended aggregates formed by Listeria monocytogenes co-cultured with Ralstonia insidiosa. Food Control 2021, 130, 108237. [Google Scholar] [CrossRef]
- Trapnell, C.; Williams, B.A.; Pertea, G.; Mortazavi, A.; Kwan, G.; van Baren, M.J.; Salzberg, S.L.; Wold, B.J.; Pachter, L. Transcript assembly and quantification by RNA-Seq reveals unannotated transcripts and isoform switching during cell differentiation. Nat. Biotechnol. 2010, 28, 511–515. [Google Scholar] [CrossRef] [Green Version]
- Arnaud, M.; Chastanet, A.; Debarbouille, M. New vector for efficient allelic replacement in naturally nontransformable, low-GC-content, gram-positive bacteria. Appl. Environ. Microbiol. 2004, 70, 6887–6891. [Google Scholar] [CrossRef] [Green Version]
- Del Campo, A.M.; Ballado, T.; De la Mora, J.; Poggio, S.; Camarena, L.; Dreyfus, G. Chemotactic control of the two flagellar systems of Rhodobacter sphaeroides is mediated by different sets of CheY and FliM proteins. J. Bacteriol. 2007, 189, 8397–8401. [Google Scholar] [CrossRef] [Green Version]
- Varet, H.; Brillet-Gueguen, L.; Coppee, J.-Y.; Dillies, M.-A. SARTools: A DESeq2-and EdgeR-Based R pipeline for comprehensive differential analysis of RNA-Seq data. PLoS ONE 2016, 11, e0157022. [Google Scholar] [CrossRef] [Green Version]
- Hsu, C.-Y.; Cairns, L.; Hobley, L.; Abbott, J.; O’Byrne, C.; Stanley-Wall, N.R. Genomic Differences between Listeria monocytogenes EGDe Isolates Reveal Crucial Roles for SigB and Wall Rhamnosylation in Biofilm Formation. J. Bacteriol. 2020, 202, e00692-19. [Google Scholar] [CrossRef] [Green Version]
- Yun, F.; Jiaju, Q.; Zhaoxin, L.; Zhiyang, F.; Yang, T.; Fengxia, L.; Haizhen, Z.; Chong, Z.; Xiaomei, B. Influence of different factors on biofilm formation of Listeria monocytogenes and the regulation of cheY gene. Food Res. Int. 2020, 137, 109405. [Google Scholar] [CrossRef]
- Liu, W.; Sun, Y.; Shen, R.; Dang, X.; Liu, X.; Sui, F.; Li, Y.; Zhang, Z.; Alexandre, G.; Elmerich, C.; et al. A chemotaxis-like pathway of Azorhizobium caulinodans controls flagella-driven motility, which regulates biofilm formation, exopolysaccharide biosynthesis, and competitive nodulation. Mol. Plant. Microbe Interact. 2018, 31, 737–749. [Google Scholar] [CrossRef] [Green Version]
- Du, B.; Gu, Y.; Chen, G.; Wang, G.; Liu, L. Flagellar motility mediates early-stage biofilm formation in oligotrophic aquatic environment. Ecotoxicol. Environ. Saf. 2020, 194, 110340. [Google Scholar] [CrossRef]
- Gotoh, Y.; Eguchi, Y.; Watanabe, T.; Okamoto, S.; Doi, A.; Utsumi, R. Two-component signal transduction as potential drug targets in pathogenic bacteria. Curr. Opin. Microbiol. 2010, 13, 232–239. [Google Scholar] [CrossRef]
- Ye, J.; Gao, M.; Zhou, Q.; Wang, H.; Xu, N.; Guo, M. The Only Chemoreceptor Encoded by che Operon Affects the Chemotactic Response of Agrobacterium to Various Chemoeffectors. Microorganisms 2021, 9, 1923. [Google Scholar] [CrossRef]
- Welch, M.; Oosawa, K.; Aizawa, S.I.; Eisenbach, M. Phosphorylation-dependent binding of a signal molecule to the flagellar switch of bacteria. Proc. Natl. Acad. Sci. USA 1993, 90, 8787–8791. [Google Scholar] [CrossRef] [Green Version]
- Dons, L.; Eriksson, E.; Jin, Y.X.; Rottenberg, M.E.; Kristensson, K.; Larsen, C.N.; Bresciani, J.; Olsen, J.E. Role of flagellin and the two-component CheA/CheY system of Listeria monocytogenes in host cell invasion and virulence. Infect. Immun. 2004, 72, 3237–3244. [Google Scholar] [CrossRef] [Green Version]
- He, Y.; Xu, T.; Fossheim, L.E.; Zhang, X.-H. FliC, a flagellin protein, is essential for the growth and virulence of fish pathogen Edwardsiella tarda. PLoS ONE 2012, 7, e45070. [Google Scholar] [CrossRef] [Green Version]
- Tang, H.; Braun, T.F.; Blair, D.F. Motility protein complexes in the bacterial flagellar motor. J. Mol. Biol. 1996, 261, 209–221. [Google Scholar] [CrossRef]
- Casey, A.; Fox, E.M.; Schmitz-Esser, S.; Coffey, A.; McAuliffe, O.; Jordan, K. Transcriptome analysis of Listeria monocytogenes exposed to biocide stress reveals a multi-system response involving cell wall synthesis, sugar uptake, and motility. Front. Microbiol. 2014, 5, 68. [Google Scholar] [CrossRef] [Green Version]
- Dons, L.; Olsen, J.E.; Rasmussen, O.F. Characterization of two putative Listeria monocytogenes genes encoding polypeptides homologous to the sensor protein CheA and the response regulator CheY of chemotaxis. DNA Seq. 1994, 4, 301–311. [Google Scholar] [CrossRef]
- Flanary, P.L.; Allen, R.D.; Dons, L.; Kathariou, S. Insertional inactivation of the Listeria monocytogenes cheYA operon abolishes response to oxygen gradients and reduces the number of flagella. Can. J. Microbiol. 1999, 45, 646–652. [Google Scholar] [CrossRef]
- Wadhams, G.H.; Armitage, J.P. Making sense of it all: Bacterial chemotaxis. Nat. Rev. Mol. Cell Biol. 2004, 5, 1024–1037. [Google Scholar] [CrossRef]

| Sample | Total Reads | Bases | Q20 1 (%) | Q30 2 (%) | GC 3 (%) | Total Mapped |
|---|---|---|---|---|---|---|
| X1 | 36,894,698 | 5,449,467,565 | 98.08 | 94.94 | 40.97 | 36,593,927 (99.1848%) |
| X2 | 34,176,440 | 5,052,294,588 | 98.08 | 94.90 | 41.42 | 32,993,382 (96.5384%) |
| X3 | 50,401,832 | 7,445,052,570 | 98.08 | 94.90 | 41.45 | 49,339,378 (97.8920%) |
| Y1 | 34,084,702 | 5,025,917,805 | 98.39 | 95.66 | 40.64 | 33,952,917 (99.6134%) |
| Y2 | 34,081,134 | 5,024,626,651 | 98.46 | 95.81 | 40.79 | 33,850,013 (99.3219%) |
| Y3 | 36,777,634 | 5,430,302,095 | 98.41 | 95.72 | 40.84 | 36,502,258 (99.2512%) |
| Functional Category | Gene Name | KO_Name | Protein | log2FoldChange |
|---|---|---|---|---|
| Flagellar assembly; bacterial chemotaxis | DR89_RS14910 | fliM | Flagellar motor switch protein FliM | 3.982754445 |
| Flagellar assembly; two-component system | DR89_RS14955 | fliC | Flagellin | 1.294521613 |
| Flagellar assembly | DR89_RS14880 | flgK | Flagellar hook-associated protein FlgK | 3.199252693 |
| Flagellar assembly | DR89_RS14845 | fliE | Flagellar hook–basal body complex protein FliE | 3.692945001 |
| Flagellar assembly | DR89_RS15005 | flhA | Flagellar biosynthesis protein FlhA | 3.37719265 |
| Flagellar assembly | DR89_RS15015 | fliR | Flagellar type III secretion system protein FliR | 3.346243552 |
| Flagellar assembly; bacterial chemotaxis; two-component system | DR89_RS14980 | motA | Flagellar motor stator protein MotA | 3.073232587 |
| Bacterial chemotaxis; two-component system | DR89_RS14945 | cheA | Chemotaxis family; sensor histidine kinase CheA | 1.975793359 |
| Bacterial chemotaxis: two-component system | DR89_RS14950 | cheY | Chemotaxis family, chemotaxis protein CheY | 3.748414246 |
| Two-component system | DR89_RS13310 | liaS | NarL family, sensor histidine kinase LiaS | 2.473963827 |
| Two-component system | DR89_RS03800 | maeA | NAD-dependent malic enzyme | 1.511261314 |
| Two-component system | DR89_RS07650 | cydB | Cytochrome d ubiquinol oxidase subunit II | −2.073407712 |
| Two-component system | DR89_RS16575 | frdA | Flavocytochrome c | −2.919069109 |
| Two-component system | DR89_RS08575 | agrA | DNA-binding response regulator | −1.516198497 |
Publisher’s Note: MDPI stays neutral with regard to jurisdictional claims in published maps and institutional affiliations. |
© 2021 by the authors. Licensee MDPI, Basel, Switzerland. This article is an open access article distributed under the terms and conditions of the Creative Commons Attribution (CC BY) license (https://creativecommons.org/licenses/by/4.0/).
Share and Cite
Li, Q.; Guo, A.; Ma, Y.; Liu, L.; Liu, W.; Zhong, Y.; Zhang, Y. Gene Analysis of Listeria monocytogenes Suspended Aggregates Induced by Ralstonia insidiosa Cell-Free Supernatants under Nutrient-Poor Environments. Microorganisms 2021, 9, 2591. https://doi.org/10.3390/microorganisms9122591
Li Q, Guo A, Ma Y, Liu L, Liu W, Zhong Y, Zhang Y. Gene Analysis of Listeria monocytogenes Suspended Aggregates Induced by Ralstonia insidiosa Cell-Free Supernatants under Nutrient-Poor Environments. Microorganisms. 2021; 9(12):2591. https://doi.org/10.3390/microorganisms9122591
Chicago/Turabian StyleLi, Qun, Ailing Guo, Yi Ma, Ling Liu, Wukang Liu, Yuan Zhong, and Yawen Zhang. 2021. "Gene Analysis of Listeria monocytogenes Suspended Aggregates Induced by Ralstonia insidiosa Cell-Free Supernatants under Nutrient-Poor Environments" Microorganisms 9, no. 12: 2591. https://doi.org/10.3390/microorganisms9122591
APA StyleLi, Q., Guo, A., Ma, Y., Liu, L., Liu, W., Zhong, Y., & Zhang, Y. (2021). Gene Analysis of Listeria monocytogenes Suspended Aggregates Induced by Ralstonia insidiosa Cell-Free Supernatants under Nutrient-Poor Environments. Microorganisms, 9(12), 2591. https://doi.org/10.3390/microorganisms9122591

